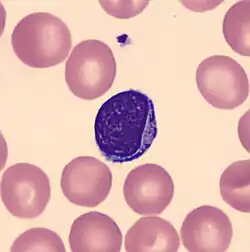

Lymphozyt

Der Lymphozyt oder Lymphocyt (von lateinisch lympha „klares Wasser“ sowie altgriechisch κύτος kýtos „Höhlung“, „Gefäß“, „Hülle“[1][2]) ist ein zellulärer Bestandteil des Blutes und gehört zu den „weißen Blutkörperchen“ (Leukozyten). Die auch im Lymphsystem vorhandenen Lymphozyten umfassen die B-Zellen, T-Zellen und die natürlichen Killerzellen. Bei Erwachsenen stellen die Lymphozyten etwa 25 bis 40 Prozent[3] der Leukozyten im peripheren Blut, also außerhalb der blutbildenden Organe, dar.
Bereits 1656 hatte der Mathematiker und Physiologe Giovanni Alfonso Borelli in der Lymphe und im Blutserum die später Lymphozyten genannten weißen Blutzellen (Leukozyten) beobachtet.[4]
Aufgabe
Die Hauptaufgabe der Lymphozyten ist die Erkennung von Fremdstoffen – wie zum Beispiel Bakterien und Viren – und deren Entfernung mit immunologischen Methoden. Dazu werden die Zellen in Milz, Knochenmark, Thymus und Lymphknoten (vermutlich auch in der Appendix vermiformis (Wurmfortsatz)) geprägt, was bedeutet, dass sie „lernen“ müssen, welche Stoffe zum Körper dieses Menschen gehören und welche als fremd anzusehen sind. Damit gehören die Lymphozyten zum adaptiven Immunsystem – zur spezifischen Abwehr – im Gegensatz zum innaten (angeborenen) Immunsystem (zum Beispiel Makrophagen). Die Lebensdauer von Lymphozyten kann zwischen einigen Stunden und mehreren Jahren betragen. Durch Zellteilung der B-Lymphozyten entstehen Plasmazellen mit einer Lebensdauer von wenigen Wochen sowie Gedächtniszellen, die mehrere Jahre bis lebenslang im Körper vorhanden sind.
Ihre Aufgabe erfüllen die Lymphozyten auf verschiedene Weise. Sie setzen beispielsweise Botenstoffe (Zytokine) frei, die andere Immunzellen und auch normale Zellen dazu bringen, potentielle Gefahren wie Bakterien und Viren zu bekämpfen. Darüber hinaus produzieren sie Antikörper, die diese „Angreifer“ als „fremd“ markieren, und zerstören infizierte Zellen.
Bildungsort und Morphologie
Die Lymphozyten entstehen als Vorläuferzellen aus pluripotenten Stammzellen im Knochenmark der platten Knochen (Becken, Brustbein, zum Teil Schädelknochen), bei Kindern zusätzlich in den großen Röhrenknochen (Arme, Beine). Die Vorläuferzellen reifen im Bursa-Äquivalent (beim Menschen das Knochenmark selbst) zu differenzierten B-Lymphozyten und im Thymus zu T-Lymphozyten. In deren weiteren Entwicklung wandern die B- und T-Lymphozyten in die sekundär-lymphatischen Gewebe, wo die Differenzierung der B-Lymphozyten durch die von T-Helferzellen bereitgestellten Zytokine unterstützt wird.
Die Zellen sind kernhaltig und haben im Blutausstrich (Pappenheim-Färbung) ein granuliertes Zellplasma. Mit zunehmendem Alter der Zellen wird der Zellkern kleiner (Zellgröße: zehn bis 15 Mikrometer).
Funktion
Es gibt verschiedene funktional unterscheidbare Typen von reifen Lymphozyten:
- αβ T-Lymphozyten
- naive (antigenunerfahrene) T-Zellen
- T-Killerzellen (CD8-positiv)
- T-Helferzellen (CD4-positiv)
- Regulatorische T-Zellen (CD4-positiv) (auch T-Unterdrückerzellen oder T-Suppressorzellen genannt)
- T-Gedächtniszellen
- NKT-Zellen
- γδ T-Lymphozyten
- naive (antigenunerfahrene) B-Zellen
- Plasmablasten (aktivierte B-Zellen)
- Plasmazellen (sezernieren Antikörper)
- Gedächtnis-B-Zellen
NK-Zellen (engl. natural killer cells) sind eine weitere Gruppe von großen granulären Lymphozyten, die weder über einen T- noch über einen B-Zell-Rezeptor verfügen und durch Freisetzung lytischer Granula infizierte Zellen (Fremdzellen, vor allem Tumorzellen und virusinfizierte Zellen) zerstören und bei der angeborenen Immunität wichtige Funktionen erfüllen. Die NK-Zellen erkennen und vernichten alle MHC-I-negativen Zellen des Organismus. Sie sind etwa zehn Mikrometer groß und besitzen einen heterochromatischen Kern. Ihre Reifung erfolgt im Knochenmark. Sie zirkulieren dann im Blut oder siedeln sich in der Milz an.
Erkrankungen
Zu den Erkrankungen des lymphatischen Systems gehören die angeborenen primären und die erworbenen sekundären Immundefekte sowie die von lymphatischen Zellen ausgehenden malignen Erkrankungen wie die Non-Hodgkin-Lymphome einschließlich der chronischen lymphatischen Leukämie, der Morbus Hodgkin, das von den Plasmazellen ausgehende Plasmozytom und die akute lymphatische Leukämie.
Im Rahmen einer HIV-Infektion kommt es zu einer Verminderung der Lymphozytenzahl.
Normalwerte
- Relativ: Die Lymphozyten machen beim Erwachsenen einen Anteil von etwa 15 bis 40 %* Absolut: 1,50 bis 4,00 Milliarden pro Liter Blut (siehe Labormedizin), entspricht 1500–4000 Zellen pro Mikroliter Blut (siehe Blutbild)
Eine Erhöhung der Lymphozytenanzahl nennt man Lymphozytose, eine Erniedrigung Lymphopenie.
Siehe auch
- Reaktiver Lymphocyt
- Granulozyt, Monozyt, Bursa Fabricii
- Hämatologie
- Differentialblutbild, ELISPOT, ELISA
Literatur
- G. A. Holländer: Immunologie – Grundlagen für Klinik und Praxis. Elsevier, München, 1. Auflage, 2006, ISBN 3-437-21301-6.
- P. J. Delves, I. M. Roitt: The immune system. In: Advance in Immunology. Band 343, 2000, S. 37–49 und 198–117.
Weblinks
Einzelnachweise
- ↑ Wilhelm Gemoll: Griechisch-Deutsches Schul- und Handwörterbuch. München / Wien 1965.
- ↑ gesundheitsinformation.de (Abgerufen am 17. September 2021)
- ↑ Rosemarie Baumann: Blut und Immunsystem. In: Michael Gekle u. a. (Hrsg.): Taschenlehrbuch Physiologie. Thieme Verlag, Stuttgart 2010, ISBN 978-3-13-144981-8, S. 244.
- ↑ Paul Diepgen, Heinz Goerke: Aschoff: Kurze Übersichtstabelle zur Geschichte der Medizin. 7., neubearbeitete Auflage. Springer, Berlin/Göttingen/Heidelberg 1960, S. 24.